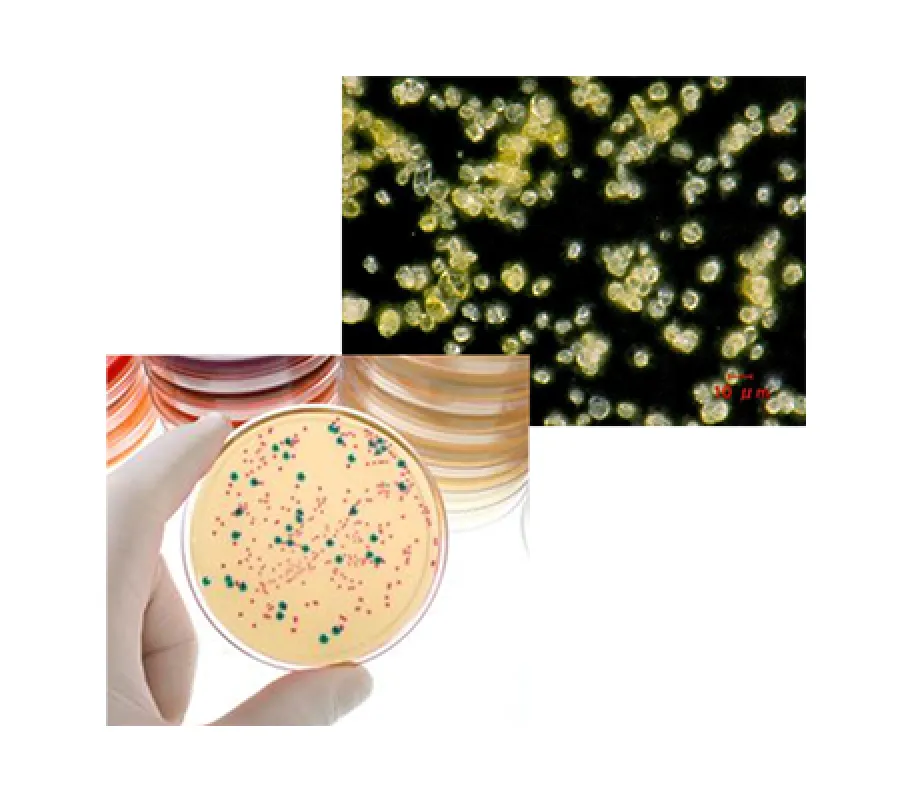
細菌培養の写真。

異物分析 事例紹介
01食品包装表面に付着した黄色い粉
直径10μm程度の黄色の丸い粒子。IR分析や培養試験等から黄色い粉は変形菌の一種と特定された。輸送に使用される木材パレットや固定用のダンネージ材などから汚染された可能性が疑われた。
- その他事例
-
食品梱包容器の破孔、破れ
02食品に混入していたフィルム状異物
異物は橙色をおびた透明なフィルム状の異物。
光学顕微鏡観察、呈色反応およびIR分析などから甲殻類の殻と特定された。食品が海産物であったことから原料由来あるいは製造工程で混入した可能性が疑われた。
- その他事例
-
虫の混入、カビ汚染、変質

03パーム油積載タンク中の異物
白色物質と黒色物質が混ざった固形物。
IR分析、X線分析及び熱分析などから、パーム油から析出した高分子量の油脂と固形炭素質(煤)の混合物であった。パーム油のヒーティング不足により高融点成分が析出した。また、外来から混入した煤などを取り込んで固形化したと考えられた。
- その他事例
-
バター、チーズなどの異物

04燃料フィルタ目詰まり物
フィルタに捕捉された重油の褐色物。
油分除去後、IR分析およびX線分析などから塗膜片や鉄さびであると特定された。タンクが劣化し塗膜やサビなど燃料油に混入した可能性が疑われた。
- その他事例
-
油の沈殿物、スラッジ、変色

05スポンジケーキの変色
ケーキのスポンジ部分が緑色に変色。
染色試験、検証実験などから、このケーキに使用されていたベリーの色素(アントシアニン)がアルカリによって緑色に変色したと特定された。ケーキに含まれるアルカリ物質との接触によって変色したと推定された。
- その他事例
-
プラスチックの変色・劣化

06付着塗料の異同識別
漁網および浮き(ブイ)に付着した赤色塗料と船舶塗料の異同識別。塗膜の樹脂成分および顔料成分を、IR分析およびX線分析で比較し、ブイに付着した塗料は船舶の塗料と同等と判断された。
- その他事例
-
針、釘などの異同識別、流出油

調査の手法と分析報告書について
異物検査では、異物の種類・状態によって、以下の分析方法から適切な手法を選択して特定を行います。
検査の手法
- 光学顕微鏡観察
- 溶解性試験
- 赤外線吸収スペクトル分析(FT-IR)
- 走査型電子顕微鏡-エネルギー分散型X線分析(SEM-EDX)
- ガスクロマトグラフ質量分析(GC-MS)
- 熱重量-示差熱分析(TG-DTA)
- 熱分解-ガスクロマトグラフ質量分析(Pyro-GC-MS)
また、スクリーニング分析や適切な前処理を行うことで迅速に対象を絞り込み、早期ご報告を心掛けています。
報告書へのこだわり
- 誰にでもわかりやすい内容
- 見やすい写真や図を駆使
- できる限り混入経路や原因までコメント




